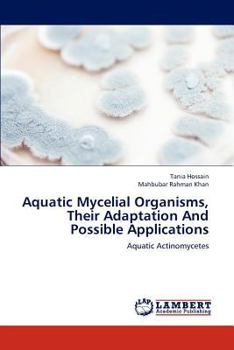
Paperback Aquatic Mycelial Organisms, Their Adaptation And Possible Applications Book

Aquatic Mycelial Organisms, Their Adaptation And Possible Applications
No Synopsis Available.
Format:Paperback
Language:English
ISBN:3659223255
ISBN13:9783659223259
Release Date:September 2012
Publisher:LAP Lambert Academic Publishing
Length:176 Pages
Weight:0.59 lbs.
Dimensions:0.4" x 6.0" x 9.0"
Customer Reviews
0 rating